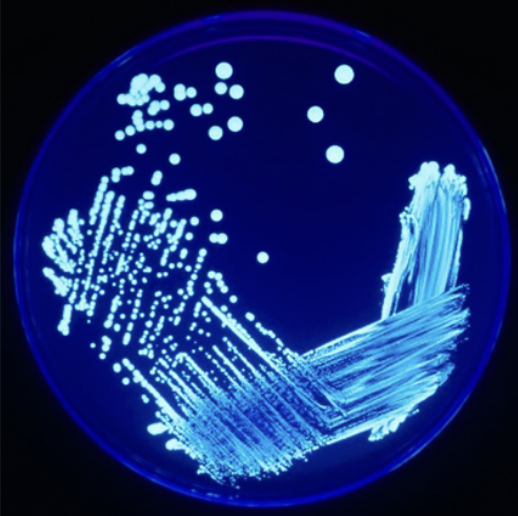
Canadian Society of Soil Science tweet media

A study in PEI emphasizes the value of site-specific soil testing to quantify nitrogen mineralization potential. Learn more in this #GroundedInSoils blog post! wp.me/pclOv9-u2

English
Canadian Society of Soil Science
1K posts

@CSSS_Soils
We are dedicated to starting conversations about #SoilScience and supporting a Canadian community of experts and enthusiasts.